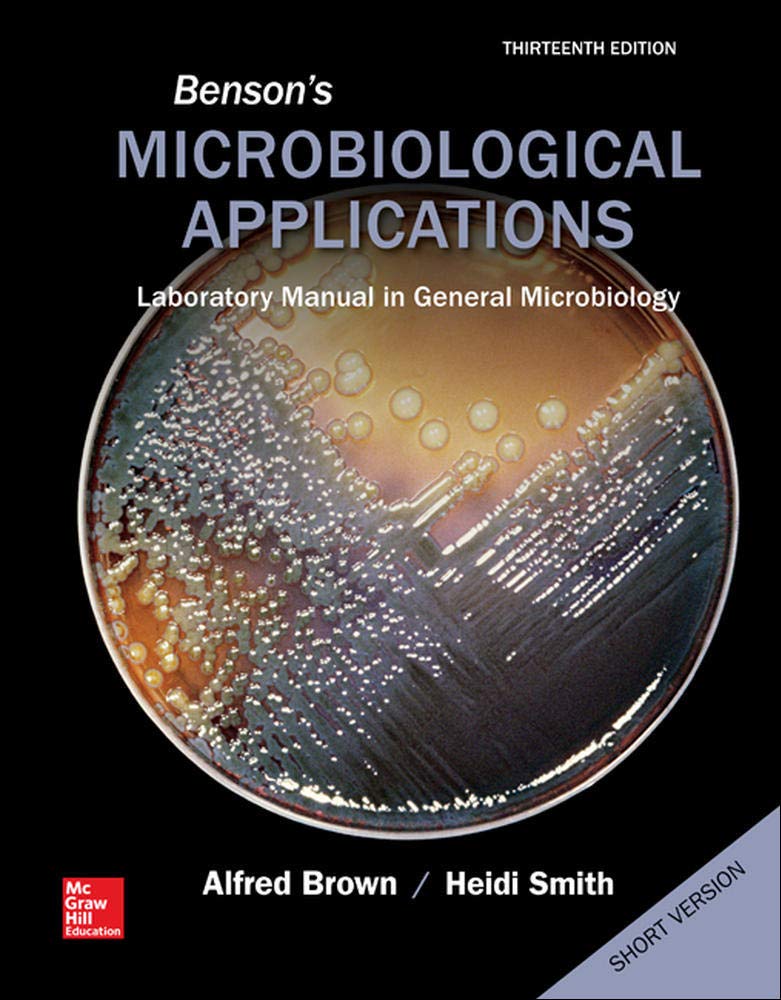
Benson'S Microbiological Applications, Laboratory Manual In General Microbiology, Short Version,New

Title
Benson'S Microbiological Applications, Laboratory Manual In General Microbiology, Short Version,New
Delivery time: 8-12 business days (International)
Benson'S Microbiological Applications Has Been The Gold Standard Of Microbiology Lab Manuals For Over 30 Years. The Selfcontained, Clearlyillustrated Exercises And Fourcolor Format Makes This The Ideal Lab Manual. Appropriate For Either A Majors Or Nonmajors Lab Course, This Manual Assumes No Prior Organic Chemistry Has Been Taken.
By changing our most important processes and
products, we have already made a big leap forward. This ranges from the
increased use of more sustainable fibers to the use of more
environmentally friendly printing processes to the development of
efficient waste management in our value chain.
⚠️ WARNING (California Proposition 65):
This product may contain chemicals known to the State of California to cause cancer, birth defects, or other reproductive harm.
For more information, please visit www.P65Warnings.ca.gov.
Shipping & Returns
Shipping
We ship your order within 2–3 business days for USA deliveries and 5–8 business days for international shipments. Once your package has been dispatched from our warehouse, you'll receive an email confirmation with a tracking number, allowing you to track the status of your delivery.
Returns
To facilitate a smooth return process, a Return Authorization (RA) Number is required for all returns. Returns without a valid RA number will be declined and may incur additional fees. You can request an RA number within 15 days of the original delivery date. For more details, please refer to our Return & Refund Policy page.
Shipping & Returns
Shipping
We ship your order within 2–3 business days for USA deliveries and 5–8 business days for international shipments. Once your package has been dispatched from our warehouse, you'll receive an email confirmation with a tracking number, allowing you to track the status of your delivery.
Returns
To facilitate a smooth return process, a Return Authorization (RA) Number is required for all returns. Returns without a valid RA number will be declined and may incur additional fees. You can request an RA number within 15 days of the original delivery date. For more details, please refer to our Return & Refund Policy page.
Warranty
We provide a 2-year limited warranty, from the date of purchase for all our products.
If you believe you have received a defective product, or are experiencing any problems with your product, please contact us.
This warranty strictly does not cover damages that arose from negligence, misuse, wear and tear, or not in accordance with product instructions (dropping the product, etc.).
Warranty
We provide a 2-year limited warranty, from the date of purchase for all our products.
If you believe you have received a defective product, or are experiencing any problems with your product, please contact us.
This warranty strictly does not cover damages that arose from negligence, misuse, wear and tear, or not in accordance with product instructions (dropping the product, etc.).
Secure Payment
Your payment information is processed securely. We do not store credit card details nor have access to your credit card information.
We accept payments with :
Visa, MasterCard, American Express, Paypal, Shopify Payments, Shop Pay and more.
Secure Payment
Your payment information is processed securely. We do not store credit card details nor have access to your credit card information.
We accept payments with :
Visa, MasterCard, American Express, Paypal, Shopify Payments, Shop Pay and more.
Related Products
You may also like
Frequently Asked Questions
- Q: What is the primary focus of Benson's Microbiological Applications? A: Benson's Microbiological Applications is primarily focused on providing comprehensive laboratory exercises in general microbiology, suitable for both majors and non-majors lab courses.
- Q: How many pages does this laboratory manual contain? A: The manual contains a total of 480 pages.
- Q: Is prior organic chemistry knowledge required to use this manual? A: No, this manual assumes that no prior organic chemistry has been taken, making it accessible for beginners.
- Q: What is the binding type of this manual? A: This laboratory manual is spiral bound, allowing for easy page turning and flat laying on the lab bench.
- Q: When was the 13th edition of this manual published? A: The 13th edition was published on January 21, 2014.
- Q: Who is the author of Benson's Microbiological Applications? A: The author of this manual is Alfred Brown.
- Q: What format does this microbiology lab manual use? A: The manual features a clearly illustrated, four-color format that enhances understanding of laboratory exercises.
- Q: What is the condition of the item being sold? A: The item is listed as acceptable condition.
- Q: Is this manual suitable for non-majors courses? A: Yes, the manual is designed to be suitable for both majors and non-majors microbiology lab courses.
- Q: What can I expect from the exercises in this lab manual? A: You can expect self-contained exercises that are clearly illustrated, helping you to grasp microbiological concepts effectively.
